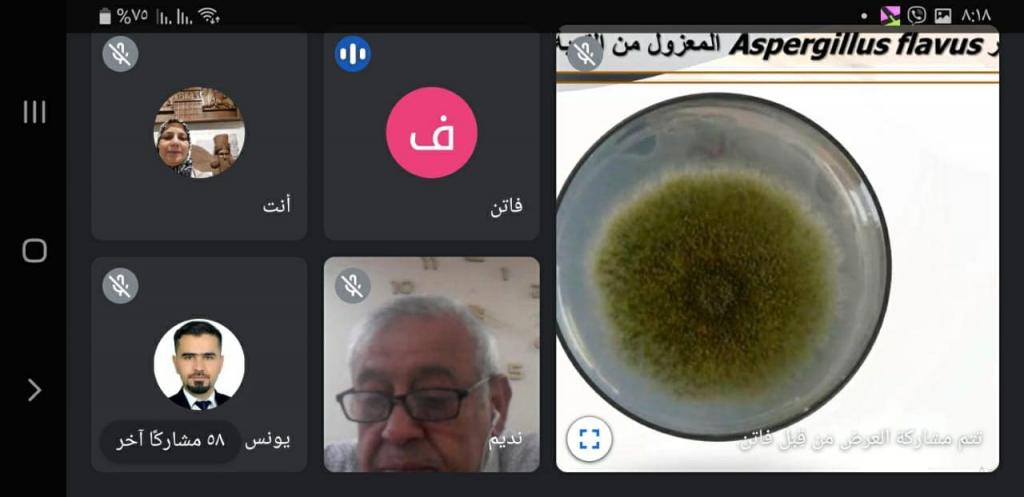
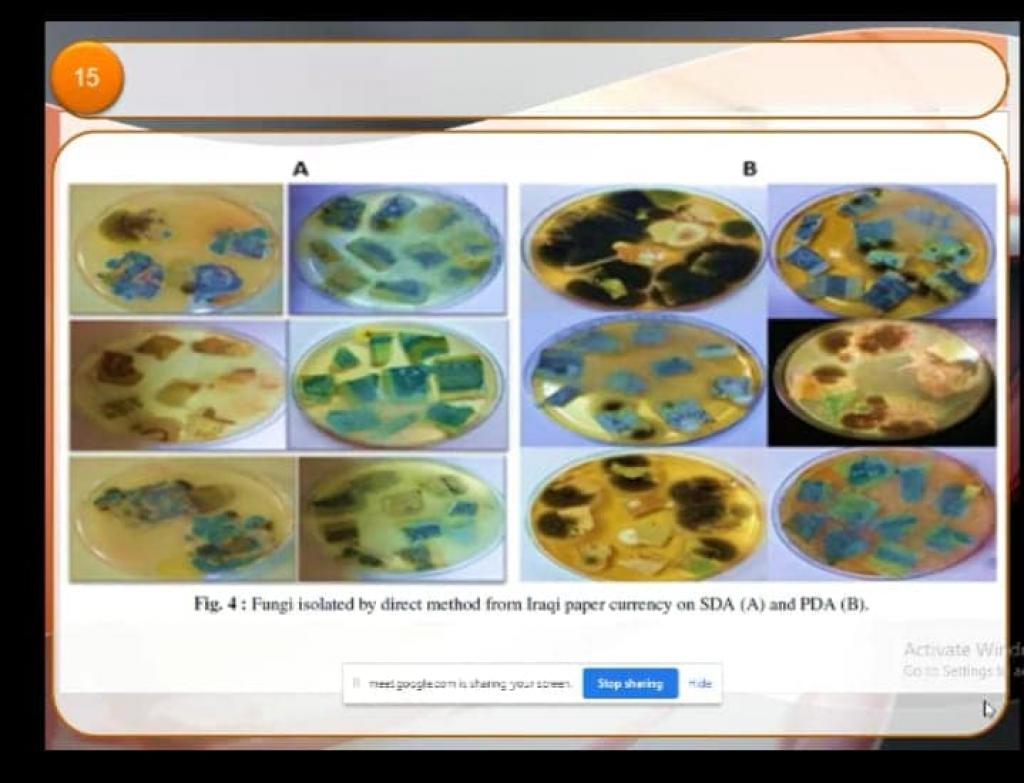

24 يونيو، 2021
ورشة عمل عن المفاتيح التصنيفية للفطريات

برعاية السيدة عميد كلية العلوم الأستاذ المساعد الدكتورة هيام عادل الطائي ، أقيمت في قسم علوم الحياة ورشة عمل بعنوان ( المفاتيح التصنيفية للفطريات ) و ذلك في تمام الساعة الثامنة من مساء يوم الأربعاء الموافق 23 حزيران 2021 حضرها السيد رئيس القسم الأستاذ المساعد الدكتور رائد سالم الصفار.نظمها كلاً من الأستاذ الدكتور نديم أحمد رمضان و الأستاذ المساعد الدكتور فاتن نوري ملا عبد و الأستاذ المساعد الدكتور ورقاء سعيد قاسم و الأستاذ المساعد الدكتور هديل أحمد خلف .تناولت الورشة ثلاث محاور هي :١-تصنيف أنواع الفطر Aspergillus من قبل د. فاتن نوري ملا عبد .٢-تصنيف أنواع فطر Alternaria من قبل د . ورقاء سعيد قاسم .٣- تصنيف أنواع فطر Fusarium من قبل د . هديل احمد خلف .شهدت الورشة حضوراً مميزاً من التدريسين من داخل وخارج العراق منها جمهورية مصر العربية ، اليمن ، الجزائر ، جامعة دهوك ، صلاح الدين وكركوك ، جامعة كويا، السليمانية ، بغداد ، المستنصرية ، و تربية الكرخ ، والكوفة ، البصرة بالإضافة الى جامعة الموصل والنور والحدباء والتقنية الشمالية و منهم طلبة الدراسات العليا و الأولية .تم إعطاء شهادة مشاركة للمشاركين في الورشة .